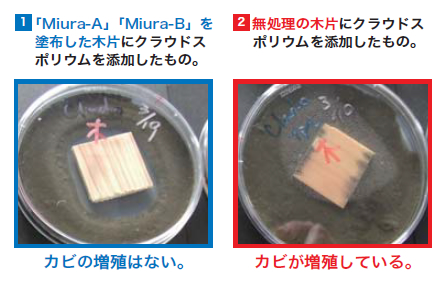

SOKENバイオ製品における微生物の働き
- 汚れを分解し、ぬめり、カビ、木腐れ、いやな臭い、すべりを防ぎます。
- レジオネラ菌などの病原性菌を抑止します。
- 作業者の健康被害、手肌の障害等の心配がありません。
- 持続性があり「きれい」な状態が長く続きます。目には見えませんが微生物が「おそうじ」をし続けてくれるからです。
- 檜に潤いを与えます。
- 排水管などの悪臭、つまり等にも効果的です。
- ◎ 天然由来だから人にも環境にも安心・安全!
- ◎ 可食微生物が酵素分解!微生物の力!
- ◎ 微生物がおそうじし続けてくれるから「きれい」な状態が長く続く!
カビを発生させない!
今使用している洗剤、『カビの原因』になっていませんか?
「ひのき風呂のカビ掃除をしても、またカビが出てきて黒ずんでしまう。」というお悩みの方は多いと思います。これは一般的な洗浄剤・漂白剤で手入れをしても、表面だけがキレイになったように見えるだけで、実はカビを根絶できていないからです。カビは汚れを栄養にして増え続けるので、汚れが残っている間は再びカビは発生します。このような掃除を続けていては、カビの発生は止められないでしょう。もしかしたら、今ご使用の洗剤が「カビの原因」を作り出してしまっているかもしれません!
「SOKEN バイオ石けん水」で毎日洗浄すると
時間が経過してもカビが発生しません!!
右の写真は、SOKEN バイオ石けん水の浸け置き液をシャーレに入れ数か月間放置したものです。
(1)は当社の『SOKEN バイオ石けん水』の漬け置き液を使用。 (2)は一般の洗浄剤を使用。
一般の洗浄剤を使用した方は、カビが増殖して汚れも付着して真っ黒になっています。当社のバイオ石けん水を使用した方は、洗浄剤の腐敗もなくわずかにカビが認識できる程度です。
特許第5922628号
「抗カビ剤の製造方法及び抗カビ方法」

抗カビ試験14 日間培養テストをご覧ください
「Miura-A」「Miura-B」(創研株式会社の特許工法で使用される洗浄剤とカビ抑止剤)の抗菌テストの試験結果です。
| 試験内容 | Miura-A とMiura-B を塗布した木片と、無処理の木片にクロカビ( クラウドスポリウム)を添加して、カビの増殖を検査。 |
|---|---|
| 対象カビ | クラウドスポリウム (最も除去と抑止が困難なカビ・アトピー型喘息・化学物質過敏症の原因となるクロカビ) ■カビ抑止テストした カビの名前 クロコウジカビ /麹カビ /アスペルギルス・バージカラー /ケタマカビ /クロカビ/カワキコウジカビ/アカカビ /アオカビ/ツチアオカビ 以上 |
| 試験結果 | ![]() |